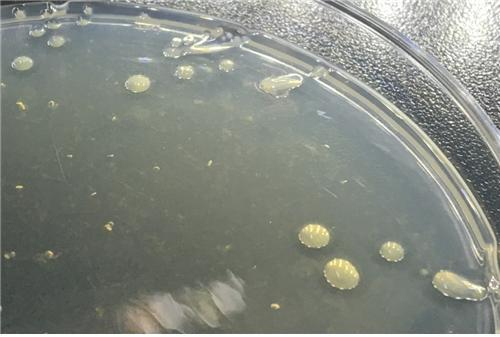
해양에서 분리된 한천분해 미생물 길비마리너스 아가릴라이티쿠스(Gilvimarinus agarilyticus JEA5) 배양 사진. KIOST 제공

KIOST, 우뭇가사리 추출한 '한천' 피부 보습 효과 발견
- 가
부분가수분해 한천의 생리활성 최초 발표
부분가수분해 한천의 히알루론산 분해 억제 효능 입증
해양에서 분리된 한천분해 미생물 길비마리너스 아가릴라이티쿠스(Gilvimarinus agarilyticus JEA5) 배양 사진. KIOST 제공
해양에서 분리된 한천분해 미생물 길비마리너스 아가릴라이티쿠스(Gilvimarinus agarilyticus JEA5) 배양 사진. KIOST 제공
![[그림] 히알루로니다아제 억제율. KIOST 제공](/nas/wcms/wcms_data/photos/2022/08/24/2022082418525578350_l.jpg) [그림] 히알루로니다아제 억제율. KIOST 제공
[그림] 히알루로니다아제 억제율. KIOST 제공
한국해양과학기술원(KIOST)은 한천(寒天· 우뭇가사리의 열수추출액의 응고물인 우무를 얼려 말린 해조가공품)을 분해하는 해양미생물로부터 한천분해효소를 분리해 부분가수분해한 한천을 만들고, 부분가수분해한 한천이 피부보습에 효과적인 히알루론산의 분해를 억제한다는 연구결과를 내놓았다.
24일 KIOST 제주연구소 이영득 연구원이 해양의약 분야 국제학술지인 ‘Marine Drugs’에 게재한 논문에 따르면, 한천을 부분적으로 가수분해한 경우, 완전히 가수분해한 한천올리고당과는 달리 히알루로니다아제를 억제하는 효과가 뛰어나다는 사실을 발견했다. 이번 연구는 부분적으로 가수분해한 한천의 효능을 최초로 발견했다는 점에서 주목할 만하다.
히알루론산은 피부, 눈, 관절 등에 존재하는 다당류로, 노화에 따라 그 양이 줄어들면서 피부가 건조해지고 잔주름이 생긴다. 히알루론산은 히알루로니다아제라고 하는 효소에 의해서 분해되며, 이 효소의 활성을 억제함으로써 피부 보습을 유지해 노화를 방지할 수 있다.
그간 한천은 단순 가공을 통한 식품으로만 활용되었으며, 완전히 가수분해할 경우 다량의 효소를 사용하기에 비용이 많이 소요되어 산업적으로 활용하기에는 어려움이 있었다.
그러나, 이번 연구결과에서 밝혀진 부분가수분해한 한천은 고형화된 일반적인 한천과 달리, 겔화되지 않는 특성 때문에 재료 가공에 제약이 없으며, 매우 적은 양의 효소만으로도 부분가수분해한 한천을 안정적으로 생산할 수 있다는 장점이 있다.
최근 해양바이오 산업을 미래 신성장산업으로 육성하는 추세에 따라, 해양생물에서 추출한 원료를 바이오 소재로 활용해 식량, 에너지, 산업소재, 의료 등으로 개발하는 움직임이 확산되고 있다. 아울러 한천을 분해한 한천올리고당을 식품, 화장품, 의약품 등에 이용하는 연구가 활발히 진행되고 있으며, 한천 가수분해 효율을 높이려는 노력 또한 이루어지고 있다.
한천올리고당은 우뭇가사리 등 해조류로부터 추출되는 한천에서 얻어지는 당으로, 최근 항비만, 항당뇨 등의 효능이 있는 것으로 알려졌다.
이에, KIOST 제주연구소 제주특성연구센터 연구진은 2015년부터 제주 연안의 해조류 서식지에서 채수한 해수로부터 길비마리너스 아가릴라이티쿠스(Gilvimarinus agarilyticus JEA5) 균주를 분리해 활성이 매우 우수한 한천분해효소를 분리하고, 유전자 재조합을 통해 대량생산 기술을 확보한 후, 작년에는 KIOST 연구소기업인 ‘(주)라라잇츠’에 기술을 이전한 바 있다.
김웅서 KIOST 원장은 “해양생물자원은 새로운 국가성장의 핵심동력으로 이번 부분가수분해한 한천의 효능 입증을 통해 향후 의약품, 화장품 등 다양한 분야의 기능성 소재로 활용될 수 있을 것으로 기대한다”며 “해양생물자원으로부터 소재를 지속 발굴하고 대량생산, 표준화 등 산업화를 촉진하는 데 기여토록 노력할 것”이라고 밝혔다.
송현수 기자 songh@busan.com
당신을 위한 AI 추천 기사
실시간 핫뉴스









